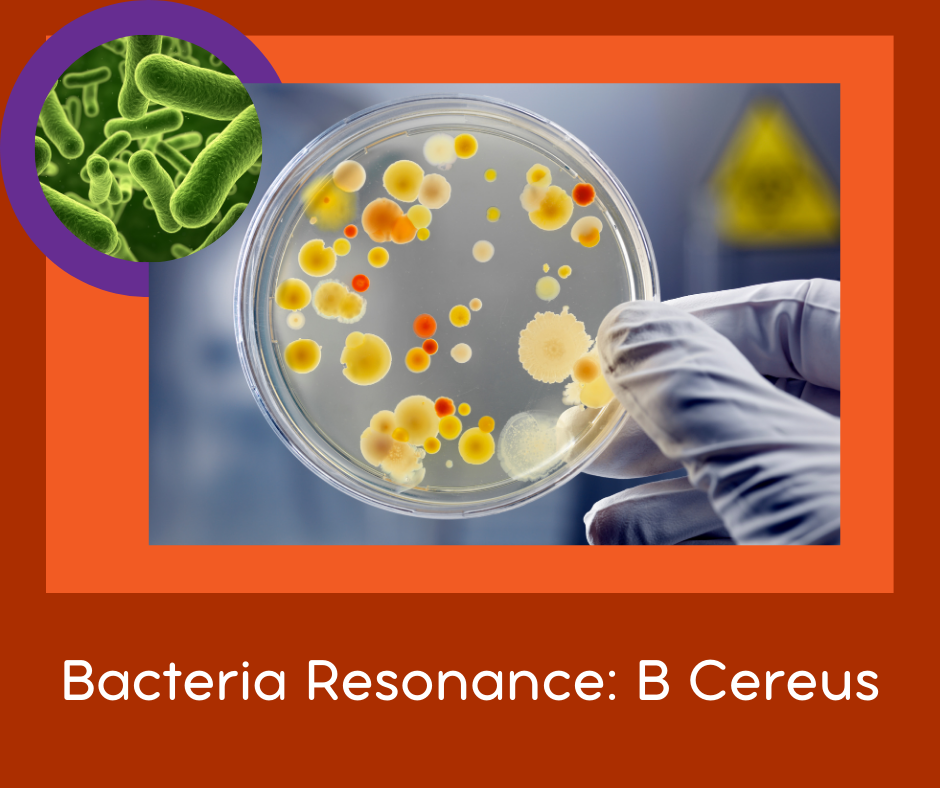

FSR for Bacterial Infections: Bacillus Cereus 2x FSR
FSR's are sound files that, when played on your body, influence the vibration of your body. The result of this is that your system can have a positive change in response to the sound.
This is the Resonance Treatment for Bacillus Cereus
Bacillus Cereus, usually a food born disease, is often found in the respiratory tract when diagnosed via Resonance evaluation. This should not be a surprise that anything put in your mouth is also breathed in.
Since most bacteria taken to your stomach can be killed by adequate Hydrochloric acid - which is missing in one's lungs - having such a respiratory infection is possible and you may not have the symptoms usually ascribed to this type of infection.
Place where you need it - most common place is over lungs, but obviously if it is in another place - place it there.
Official Name: Bacillus Cereus
- Baccilus Cereus P-SMS 5 min.ogg (5 mb)
- Baccilis Cereus and Anthracus Extra P-SMS 3min.ogg (1.1 mb)

